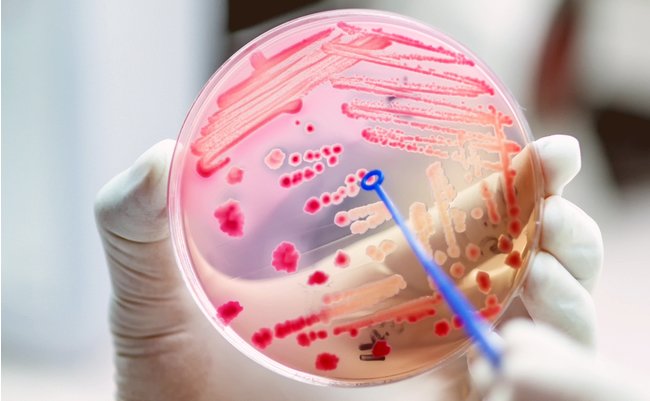

アメリカの疾病管理センターが2019年11月に6年ぶりに発表した薬剤耐性脅威レポートの内容について、「日本も含めた世界的なもので深刻な状況」と警鐘を鳴らすのは、メルマガ『ドクター徳田安春の最新健康医学』の著者で沖縄在住現役医師の徳田先生です。徳田先生は、今回挙げられた新規2つを含む5つの菌についてその症状や対策を解説。風邪などウイルス性の病気で抗菌薬を処方する医師にも、要求する患者にも問題があると、正しい対処法を伝えています。
予想を超える深刻な状況。薬剤耐性緊急脅威菌とは?
2019年11月、米国疾病管理センターは薬剤耐性脅威レポート2019を発表した。前回が2013年だったので、6年ぶりのレポート。今回の報告は、すでに脅威が以前の予想より大変深刻な状況になっているとしている。
1年間にアメリカでは、280万人が薬剤耐性菌による感染症にかかり、少なくとも3万5000人死亡しているとの報告だ。院内感染の原因菌で最も多い、クロストリジオイデス・デフィシル菌は年間22万3900ケースであり、このうち少なくとも1万2800人が死亡と報告している。
これはアメリカだけの問題ではなく、日本も含め世界的なものだ。日本の発生数と死亡数もかなりの数になっているであろう。クロストリジオイデス・デフィシル菌は日本の院内感染症としても20年以上前からよくみられていた。下痢や発熱をきたし、重症では大腸(結腸)が巨大化し、全身の中毒症状をもたらす。これは中毒性巨大結腸症と呼ばれる状態だ。死亡率も高い。抗菌薬を投与された入院患者さんがリスク投与となる。
今回の薬剤耐性脅威レポートは、薬剤耐性緊急脅威菌として5つの菌を挙げた。緊急に対策が必要という意味。ここでの菌は細菌と真菌を意味する。真菌とはカビのこと。緊急脅威には、クロストリジオイデス・デフィシル以外に、下記の4つの菌を含む。カルバペネム耐性腸内細菌科細菌、薬剤耐性淋菌、アシネトバクター、そしてカンジダ・アウリスだ。このうち、アシネトバクターとカンジダ・アウリスは今回のレポートで新たに緊急脅威菌に含まれた。